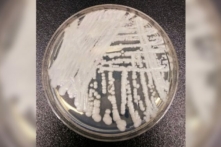

Dữ liệu mới của CDC: Tỷ lệ tự kỷ đang gia tăng
Theo dữ liệu mới từ Trung tâm Kiểm soát và Phòng ngừa Dịch bệnh Hoa Kỳ (CDC), ngày càng có nhiều trẻ em Hoa Kỳ mắc chứng tự kỷ hơn bao giờ hết.
Trong một nghiên cứu được công bố trên cuốn gần như là tạp chí của cơ quan này, các nhà nghiên cứu cho biết, cứ 1 trên 36, hay 2.8%, trẻ em 8 tuổi mắc chứng tự kỷ ở 11 cộng đồng trong nước.
Con số này tăng từ 1/44 (2.27%) vào năm 2018 và 1/150 (0.66%) vào năm 2002.
Những cộng đồng này đều là một phần của Mạng lưới Theo dõi Bệnh tự kỷ và Khuyết tật Phát triển (Autism and Developmental Disabilities Monitoring Network), một chương trình do CDC tài trợ được thành lập vào năm 2000 “nhằm thu thập dữ liệu để hiểu rõ hơn về số lượng và đặc điểm của trẻ em mắc chứng rối loạn phổ tự kỷ và các khuyết tật phát triển khác sống ở các khu vực khác nhau của Hoa Kỳ.”
Tự kỷ, hay rối loạn phổ tự kỷ, là một khuyết tật phát triển có thể biểu hiện theo nhiều cách khác nhau, điển hình bao gồm khó truyền đạt và giao tiếp với người khác.
Mạng lưới này có ở 11 tiểu bang, trong đó có Arkansas, Maryland, và Tennessee.
Các nhà nghiên cứu xem một đứa trẻ là mắc chứng tự kỷ sau khi xem xét hồ sơ y tế và tìm thấy một tuyên bố chẩn đoán bệnh tự kỷ trong một đánh giá, một phân loại bệnh tự kỷ trong giáo dục đặc biệt, hoặc một mã y tế về bệnh tự kỷ.
Bé trai có nhiều khả năng mắc chứng tự kỷ hơn bé gái.
CDC cho biết các cộng đồng này “không đại diện cho toàn bộ Hoa Kỳ.” Các chương trình liên bang khác báo cáo về sự phổ biến của chứng tự kỷ thường phải mang tính đại diện trên toàn quốc. Ước tính cuối cùng trên toàn quốc ở thanh thiếu niên, hoặc trẻ em từ 3 đến 17 tuổi, là 2.9%.
Một bài nghiên cứu mới khác được Báo cáo Hàng tuần về Bệnh tật và Tử vong của CDC công bố, nghiên cứu về trẻ em 4 tuổi trong cùng một mạng lưới theo dõi chứng tự kỷ, cho thấy rằng nhiều trẻ em 4 tuổi được chẩn đoán mắc chứng tự kỷ từ năm 2016 đến đầu năm 2020 hơn so với bốn năm trước đó.
Cả các nhà nghiên cứu và các quan chức khác của CDC đều không thể nói chắc chắn điều gì đã thúc đẩy sự gia tăng bệnh tự kỷ.
Một số quan chức và chuyên gia tin rằng tỷ lệ tự kỷ không tăng. Họ nói rằng đó là sự gia tăng các chẩn đoán.
Bà Kelly Shaw, một nhà dịch tễ học của CDC và là một trong những nhà nghiên cứu này, nói với TODAY: “Dự đoán tốt nhất của chúng tôi, phù hợp với sự gia tăng chung về các tỷ lệ mắc bệnh tự kỷ, đó là khả năng tiếp cận đánh giá và chẩn đoán công bằng hơn.”
Theo Autism Speaks, một tổ chức bất vụ lợi chuyên cải thiện cuộc sống của người tự kỷ, các nguyên nhân gây ra bệnh tự kỷ vẫn đang được nghiên cứu nhưng bao gồm các yếu tố di truyền và rủi ro môi trường như tuổi cha mẹ cao. Một bài báo gần đây đã kết luận rằng di truyền học mang một rủi ro đáng kể. Các nghiên cứu khác đã cho thấy rằng việc tiếp xúc với một số vật liệu nhất định, chẳng hạn như nhôm, có thể là một nguyên nhân.
Các nhóm bên ngoài đã khiển trách CDC vì đã không điều tra nguyên nhân gốc rễ của sự tăng vọt trong ước tính tỷ lệ mắc bệnh tự kỷ.
Thanh Tâm biên dịch
Quý vị tham khảo bản gốc từ The Epoch Times
Mới nhất
Tiêu điểm
Bình luận
Email